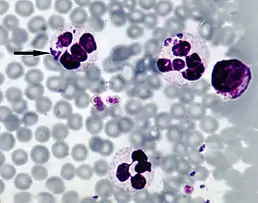

Анаплазма
Анаплазми (лат. Anaplasma) — рід родини Ehrlichiaceae порядку Rickettsiaceae: кровопаразити жуйних тварин і людини.
? Анаплазма | ||||||||||||
|---|---|---|---|---|---|---|---|---|---|---|---|---|
![]() | ||||||||||||
| Біологічна класифікація | ||||||||||||
| ||||||||||||
| Anaplasma, Theiler, 1910 | ||||||||||||
Посилання | ||||||||||||
| ||||||||||||
Форма тіла округла, діаметр до 1 мкм. Розмножуються розподілом. Поширені анаплазми по всій земній кулі.Спричинюють захворювання крові (анаплазмози). У червоних кров'яних клітинах великої рогатої худоби паразитує Anaplasma marginale typus, у овець і кіз ≈Anaplasma ovis. Гранулоцитарний анаплазмоз людини спричинює Anaplasma phagocytophilum
This article is issued from Wikipedia. The text is licensed under Creative Commons - Attribution - Sharealike. Additional terms may apply for the media files.